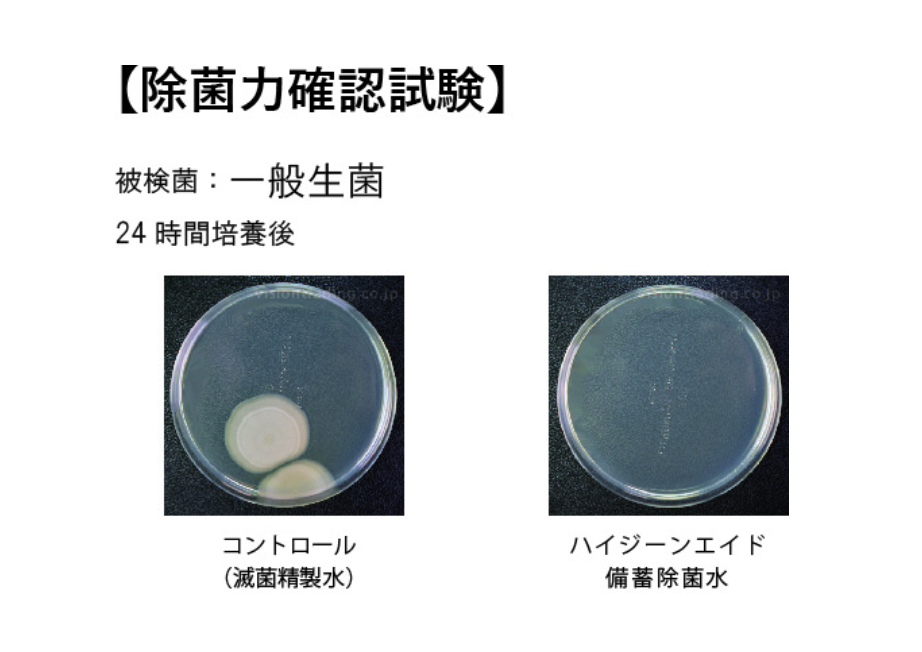

各種品質管理試験
除菌力・安定性・安全性
などの品質管理
お客様に安心して衛生管理を行っていただけるよう、
製品の品質を確認する自社試験および
外部委託試験を定期的・継続的に行っています。
自社試験
一般生菌試験
安定性試験
経年による製品汚染確認試験
外部委託試験
ウィルス不活化試験
除菌効力測定試験
食品添加物との同等性
長期保全性
お客様に安心して衛生管理を行っていただけるよう、
製品の品質を確認する自社試験および
外部委託試験を定期的・継続的に行っています。
自社試験
一般生菌試験
安定性試験
経年による製品汚染確認試験
外部委託試験
ウィルス不活化試験
除菌効力測定試験
食品添加物との同等性
長期保全性